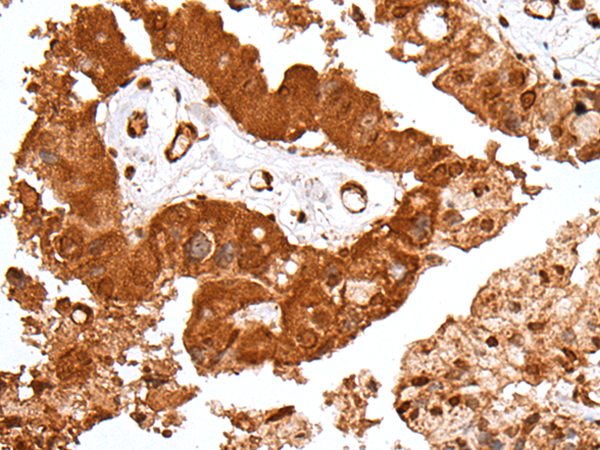
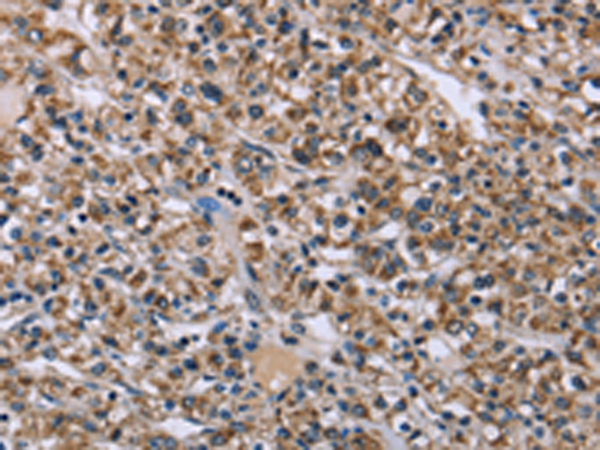

-
分类: 科研抗体货号: P08279别名:应用: IHC反应种属: Human, Mouse
-
分类: 科研抗体货号: P08278别名: BIR; HHF2; PHHI; IKATP; TNDM3; KIR6.2应用: IHC反应种属: Human, Mouse, Rat
-
分类: 科研抗体货号: P08299别名: RPR; BOTV; REGR; EXTR1; EXTL1L应用: IHC反应种属: Human, Mouse
-
分类: 科研抗体货号: P08277别名: KNSL3应用: IHC反应种属: Human
-
分类: 科研抗体货号: P08317别名: dJ1187M17.5应用: IHC反应种属: Human
-
分类: 科研抗体货号: P08298别名: ETS2IT1应用: WB反应种属: Human, Mouse
-
分类: 科研抗体货号: P08275别名: EIG121应用: IHC反应种属: Human, Mouse
-
分类: 科研抗体货号: P08316别名:应用: IHC反应种属: Human
-
分类: 科研抗体货号: P08297别名: ETK; PSCTK2; PSCTK3应用: IHC反应种属: Human, Mouse
-
分类: 科研抗体货号: P08273别名: EIF-5; EIF-5A应用: IHC反应种属: Human, Mouse, Rat

鄂公网安备42018502007531号
鄂公网安备42018502007531号

